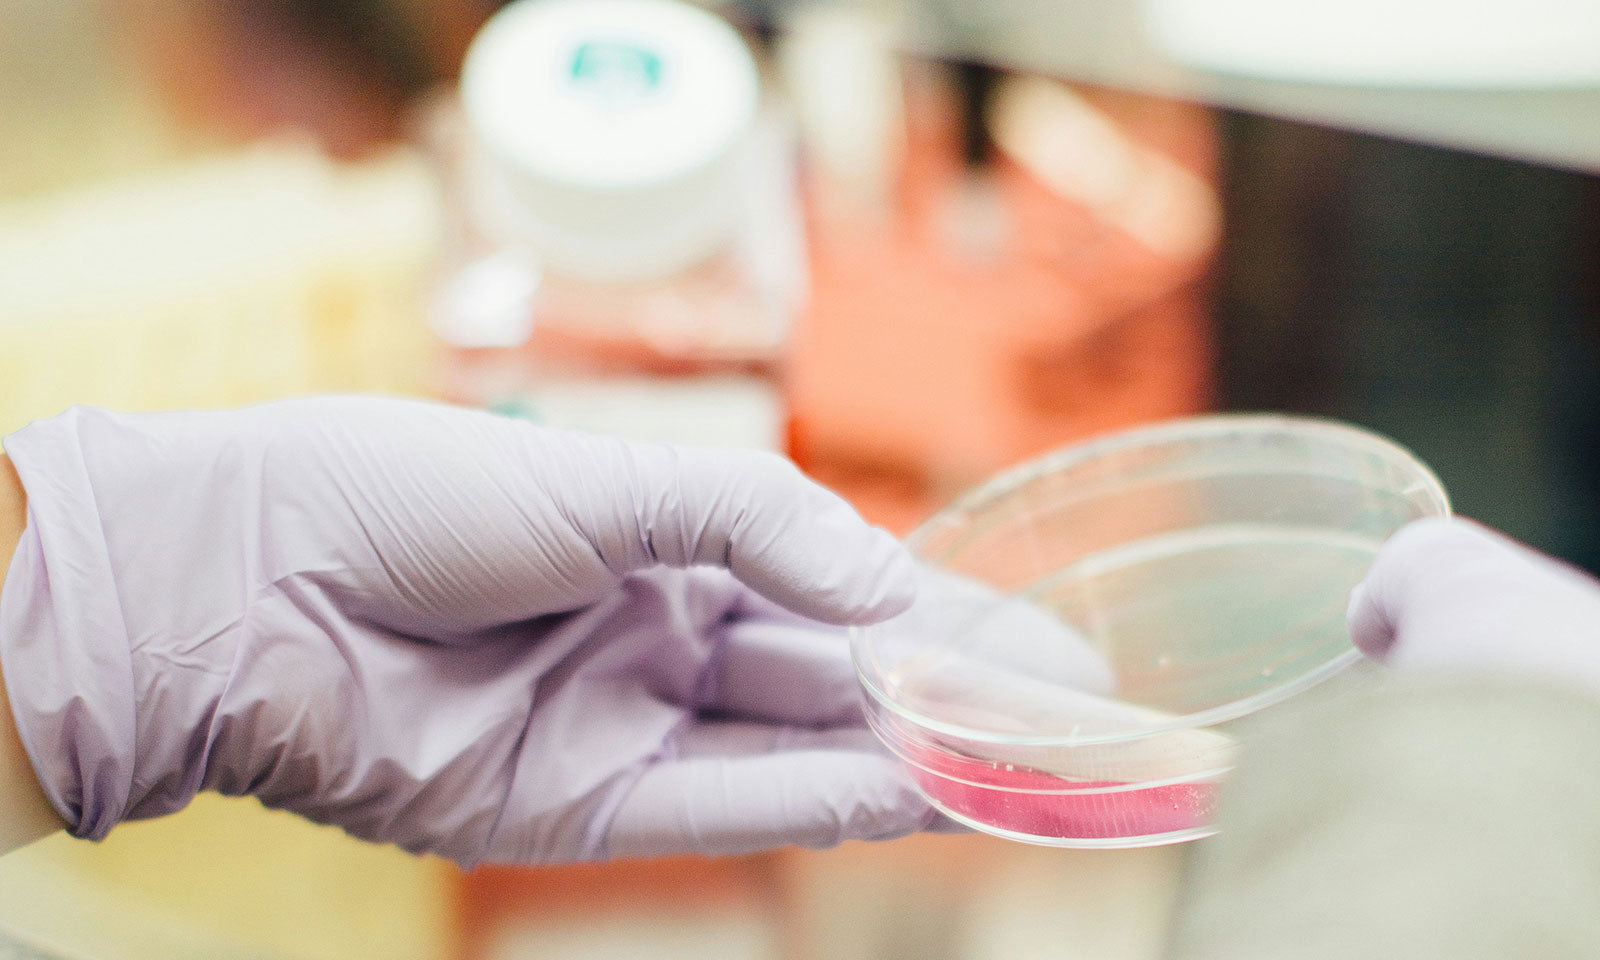
TYPO3 muko.info

Vereinswebseite für für Betroffene und Angehörige, Behandler, Therapeuten und Wissenschaftler
Der Mukoviszidose e.V. setzt sich für die Belange von Menschen mit Mukoviszidose und der ihrer Angehörigen ein.
Die TYPO3-Webseite des Mukoviszidose e.V. bietet eine Vielzahl an Informationen über die Krankheit und das Leben mit ihr, den Stand der Forschung, Neuigkeiten und Termine sowie verschiedenste Angebote, selbst aktiv zu werden, sei es als Spender/in oder zukünftiges Mitglied.
Seit Jahren führt fixpunkt immer wieder Anpassungen durch. U.a. wurde der ehemals externe Blog integriert, die Navigation neu strukturiert, zuletzt wurde die Seite zu einem hohen Grad barrierefrei gemacht (da die Farben nicht geändert werden sollten, wurde ein Button für höheren Kontrast integriert).



Mukoviszidose e.V.
Der in Bonn ansässige Mukoviszidose e.V. – Bundesverband Cystische Fibrose (CF) vernetzt seit seiner Gründung 1965 von Mukoviszidose betroffene Patienten, deren Angehörige, Ärzte, Therapeuten und Forscher. Ziel ist, durch das Bündeln unterschiedlicher Erfahrungen, Kompetenzen und Perspektiven ein möglichst selbstbestimmtes Leben mit der Krankheit für die Betroffenen zu ermöglichen. Der Verein setzt sich für Hilfe zur Selbsthilfe, verbesserte Therapiemöglichkeiten und Forschungsförderung ein. Darüber hinaus macht er sich für die Belange der Betroffenen gegenüber Entscheidungsträgern in Politik, dem Gesundheitswesen und der Wirtschaft ein. Um diese Aufgaben und Ziele zu erreichen, ist der gemeinnützige Verein auf die Unterstützung engagierter Spender und Förderer angewiesen.